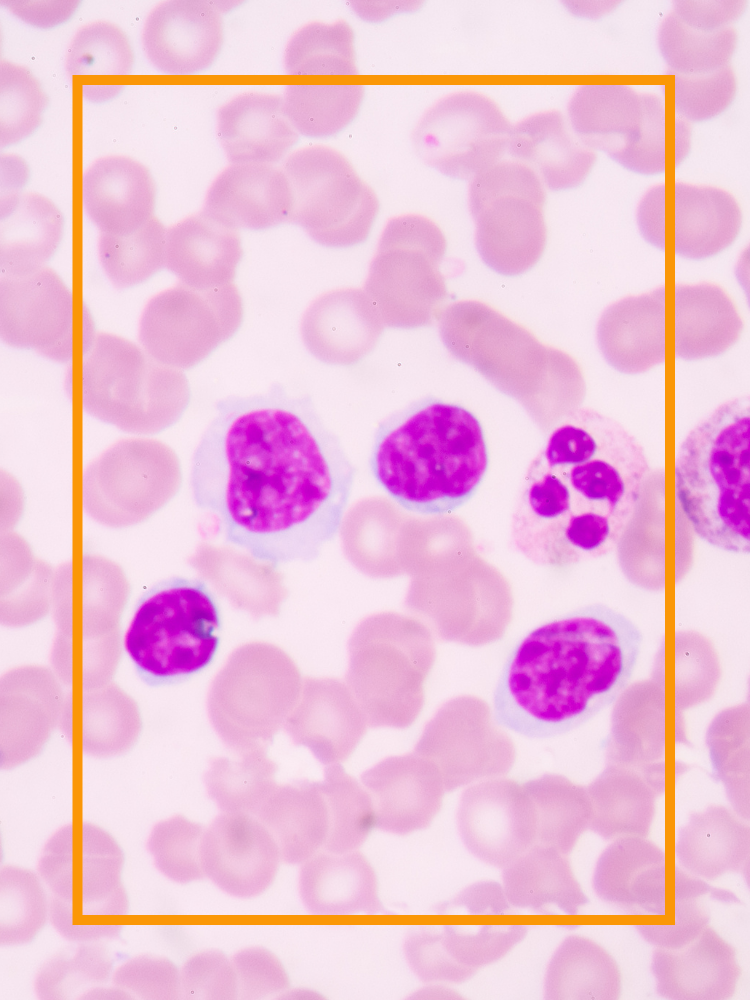
White blood cells in a smear

Treating cancer.
28% of patients received chemotherapy and 27% received radiotherapy, either as standalone treatments or in combination with tumour-removal surgery and other therapies.
Our researchers are improving outcomes for cancer patients worldwide by developing new therapies and enhancing existing ones. They’re working with industry and entrepreneurs to assess and develop innovations to bring life-saving discoveries into clinical environments.
Oxford’s experts are looking ways to turn our own immune systems against cancerous tumours and how other viruses can be manipulated into targeting cancer.
By building on the world-renowned Oxford-AstraZeneca COVID-19 vaccine, they’re creating immunotherapy jabs to tackle cancer too.
Tags:


Immuno-oncology
Immuno-oncology at Oxford
Treatments that take advantage of the body’s own immune system to target cancer are very new, and the full potential of immuno-oncology hasn’t yet been reached.
The teams at Oxford Cancer aim to realise the long-term benefits of immunotherapy by developing new treatments, broadening the impact of existing ones, and reducing treatment side effects – transforming cancer treatment for future patients and working closely with clinical partners to make sure that their developments benefit real people
Oxford is home to a range of researchers with expertise in the immune system’s detection of, and response to, cancer.
There are 85 related research groups at the University, spread across the city with hubs at the Dunn School of Pathology, the Weatherall Institute of Molecular Medicine (MRC Human Immunology and Molecular Haematology units), and Ludwig, Kennedy, Jenner and Medawar Institutes.
Immuno-oncology is one Oxford Cancer’s key strategic themes, and one of the areas benefitting from an £11 million award for the CRUK Oxford Centre.
Improving immunotherapy response
Immunotherapy works against a range of cancers, but some therapies aren’t effective; Oxford researchers are hoping to understand and change this.
One approach, immune checkpoint blockade therapy, can be effective in helping the immune system kill cancer cells, but it's ineffective in the majority of cancer patients. Research by Professor Yang Shi’s group is hoping to change this and eradicate tumours that respond poorly to such immunotherapies.
By understanding more about the molecular mechanisms, the team hope that this could enable the design of new strategies that can enhance immune checkpoint therapy to benefit more patients.
‘By identifying the factors that determine response to immunotherapy we will be better able to understand why some patients do not benefit’
Also investigating immune checkpoint blocker therapy, researchers from the Fairfax lab have identified specific aspects of the immune system that are important in determining the response to the therapy’s use as a treatment for melanoma.
The work, which was led by DPhil students Robert Watson and Orion Tong, determined which components of the immune response are most impacted by checkpoint blockers.
Supported by the Wellcome Trust, NIHR Oxford Biomedical Research Centre and CRUK, the researchers’ findings have important implications for patient care; the long-term clinical benefit of immunotherapy for treating melanoma can be predicted from patient blood samples.
Turning viruses against cancer
T cells, a key part of our immune system, can be controlled by cancer through what are called ‘checkpoint proteins’. One way to prevent immune cell suppression is to interfere with these interactions, allowing the immune system to recognise and fight back against cancer cells.
Though viruses commonly cause harmful diseases, genetically modified ‘oncolytic’ viruses have been used as cancer therapies as they can directly kill cancer cells and be used to deliver other treatments.
Researchers from Oxford’s Seymour Lab have investigated the use of an oncolytic virus, herpes virus-1, to express an antibody targeted at one of these checkpoint proteins.
Once it has infected a tumour cell, the virus replicates, eventually causing the cell to burst, infecting and spreading to neighbouring tumour cells. This makes the programmed herpes virus the perfect vector for carrying targeted immunotherapy drugs to help with the destruction of cancer.
Researchers have also equipped a carcinoma cell-killing virus with a protein that enables it to target and kill adjacent cells that have been tricked into protecting cancer from the immune system.
This is the first time that cancer-associated cells within solid tumours have been specifically targeted in this way.
Funded by the Medical Research Council, CRUK, the Kay Kendall Leukaemia Fund and the NIHR Oxford Biomedical Research Centre, the therapy was successfully tested on fresh human cancer cells, including prostate cancer tumours. This innovative delivery system could improve outcomes for patients whose cancer is resistant to current treatment.

Novel therapeutics
The development of new therapies and improvement of existing ones is a key theme of Oxford Cancer’s research and a crucial step in continuing to improve cancer cure rates.
Only 50% of patients with cancer can expect to be cured, or live for more than 10 years post-diagnosis, with the currently available combinations of surgery, radiation therapy and various medications.
Research into novel therapeutics is therefore a crucial aspect to improving cancer outcomes. It is one of the areas of Oxford cancer research benefitting from investment by Cancer Research UK.
By ensuring that insights from fundamental scientific advances, such as those in physical sciences and drug discovery, and cell biology and tissue physiology, are used to improve cancer treatments, Oxford’s experts are hoping to improve to improve cancer surgery and radiotherapy, target drug delivery and develop new cancer medicines.

Cancer drugs
Developing new drugs and repurposing drugs for other diseases
Oxford’s diverse community of researchers is sharing expertise and applying a range of physical science and engineering principles to develop and deliver drugs that will improve patient care and outcomes. They’re also collaborating with clinicians and biologists to explore novel therapies that can improve existing treatments and therapies.
Sometimes this means digging into the past. The fungus Cordyceps sinensis, found in the Himalayas, has been used to treat cancer and other inflammatory diseases in traditional Chinese medicine for hundreds of years. However, most of the cancer-destroying fungus breaks down before it reaches the tumour.
Working with partners in industry, Oxford teams have assessed the development of an element of the fungus that has been turned into a clinical therapy. Led by Professor Sarah Blagden and Dr Hagen Schwenzer, teams found it to have 40 times greater potency for killing cancer cells than its parent compound.
The technology used by Oxford’s industry partner NuCana to achieve this, ProTide, is a novel approach to delivering drugs into cancer cells. It has already been successfully used in anti-viral drugs that treat infections such as Hepatitis C, Ebola and COVID-19.
As well as utilising knowledge from the delivery of different drugs, experts at Oxford are exploring whether the drugs themselves can be reprogrammed to treat cancer.
Results from the ATOM clinical trial suggest that the anti-malarial drug Atovaquene has the potential to make cancers behave less aggressively, improving the impact of everyday cancer treatments.
‘I’m delighted that the results from the study are so positive so that we can take the next step towards repurposing a well-established drug as a new, effective anti-cancer treatment’
Also used for pneumonia, Atovaquene successfully reprogrammed the tumour cell metabolism, enabling more oxygen to be present around the tumour, which makes it more susceptible to treatment.
Following on from the ATOM clinical trial, the ARCADIAN clinical trial will investigate the efficacy of Atovaquene in combination with chemoradiotherapy to improve patient survival.
Improving existing cancer drugs and overcoming drug resistance
In addition to developing new forms of cancer drugs, and repurposing drugs developed for other infections and diseases, researchers are constantly seeking to reduce side effects from, and improve the efficacy of, drugs that are already used in cancer treatment.
Many drugs used in cancer treatment result in side effects due to the damage inflicted on healthy, non-cancerous cells. An important goal in the development of drug therapies is to target drugs in a way that will only kill cancerous cells.
This is something that the Newstead group, in collaboration with colleagues from the National Cancer Institute (USA), are seeking to address.
Their work into how folate, a vitamin essential for cell growth, is absorbed into cells, could pave the way for the development of targeted anti-cancer drugs.
‘This new fundamental research could, in the long run, result in major advances in drug development and ultimately help more cancer patients’
Despite enhancements in cancer drugs, some patients may still become resistant to their treatment because of genetic mutation.
A team of researchers from the Department of Chemistry have investigated resistance to the drug Ivosidensib, used to treat acute myeloid leukaemia (AML), a cancer of the blood and bone marrow. By focusing on the mechanism behind an acquired genetic mutation, they hope to increase our understanding of what causes the resistance, with the aim to show that the resistance can be overcome.
‘We’re constantly seeking new therapies that are capable of addressing resistance and enabling a durable response in patients with cancer’
Some patients might not develop drug resistance, but they may need re-sensitising to their cancer treatment.
In August 2021, the first patient was dosed with a new drug aiming to improve treatment options for melanoma and Non-Small Lung Cancer (NSCLC) and re-sensitise patients who have tumours that are resistant to checkpoint therapy, a form of immunotherapy.
The IMP-MEL study, which is supported by the NIHR Oxford Biomedical Research Centre, is being led by Professor Mark Middleton, with supply and funding from Portage Biotech Inc. By re-sensitising patients, researchers hope to make existing drugs more effective and appropriate for the treatment of cancer.
Work is being undertaken to develop new drugs, re-purpose and enhance existing ones, as well as to re-sensitise patients to improve treatment. But what happens if a cancer is ‘undruggable’?
Through an alliance between industry and academia, a multidisciplinary research collaboration has shown that proteins previously thought to be ‘undruggable’ could be targeted, meaning that drugs could be created to treat the cancers they cause.
Improving drug delivery
Once cancer drugs have been developed, it’s important to ensure that they’re targeted at the optimal location for effectiveness in treating disease.
Using ultrasound and lipid drug carriers, Oxford researchers have developed a new way to improve the targeting of cancer drugs to tumours.
Lipid:
One of a group of naturally occurring compounds that are soluble in solvents such as chloroform or alcohol, but insoluble in water - f or example, fats and steroids
Known as the TARDOX trial, conducted at the Churchill Hospital in Oxford, this work demonstrated that radiology not only has an evolving role in cancer diagnosis, but also in planning, guiding and monitoring therapy.
Building on the success of the TARDOX trial, the PanDox study, supported by the NIHR Oxford Biomedical Research Centre, has set out to see whether chemotherapy drugs can reach pancreatic tumours more effectively with a heat-sensitive shell and focused ultrasound.
Researchers at Oxford are also seeking revolutionary methods for the delivery of chemotherapy drugs. Professor Eleanor Stride has been working to create and control micro-bubbles that are injected into the blood stream and magnetically guided to the site of the cancer.
These bubbles then burst via ultrasound, releasing the drug in an approach that would avoid the widespread destruction of healthy cells that is unavoidable with present treatments.
from Born to Engineer

Radiotherapy
Clinical oncologists, molecular biologists, medical physicists and mathematicians are just some of the researchers that form Oxford’s large multidisciplinary group of experts aiming to improve the efficacy of radiation therapy.
Communicating the risks and benefits of radiotherapy
Forms of radiation therapy have been used as a treatment for cancer for over a hundred years, and they continue to be a standard treatment option for many cancer types today.
Like most cancer treatments, radiation comes with its own risks.
Giving patients more information about their treatment options, particularly for patients with Hodgkin lymphoma being offered radiotherapy, is the focus of a study by Dr Rebecca Shakir of Oxford Population Health.
Dr Shakir’s study is devising a tool to give patients individualised information on treatment benefits and risks. Funded by the National Institute for Health Research and Cancer Research UK, it also hopes to move the conversation about radiotherapy risks and appropriateness earlier in the cancer process, so that patients have more time to make decisions about their therapies.
Improving radiotherapy techniques
Oxford’s experts are also trying to ensure accuracy of radiotherapy treatment.
One form of radiotherapy, proton-beam-therapy (PBT), is becoming increasingly important for cancer treatment. However, there is some uncertainty around its delivery as well as the risk of the therapy over- or under-dosing tissue.
To help fine tune radiotherapy doses, Dr Anna Vella and Professor Frank Van Den Heuvel are developing an imaging device for quality assurance assessment use in daily clinical practice. Entitled CAPULET, the project is funded by Innovate UK and Cancer Research UK.
Professor Bart Cornelissen and Dr Tiffany Chan are working on an innovative new type of radiotherapy designed to hunt out cancer event after it has spread thanks to funding from the charity Prostate Cancer Research (PCR).
Combining radiotherapy with other treatments and technologies
As with using drugs to treat cancer, radiotherapy can be used in combination with other therapies to improve patient outcomes.
For example, recent work by Richard Bryant and Professor Freddy Hamdy explored the potential for radiotherapy to be used in combination with vascular targeted photodynamic therapy (VTP) to treat prostate cancer.
They found that, in isolation, fractioned radiotherapy or VTP can delay tumour growth, but combination therapy suppressed tumour growth to a greater extent than either treatment alone.
Combination therapy:
Therapy that combines several types of treatment to improve results. Usually, a combination of surgery with radiotherapy and/or chemotherapy for the treatment of malignant tumours
A study produced in partnership with GenesisCare also highlighted the role MRI could play in improving patient outcomes for pancreatic cancer, with survival rates almost doubling when MRI-guided stereotactic ablative radiotherapy (SABR) was used as a treatment.
Partnering with hospitals to deliver first of its kind care
The MRIdian technology used to improve patient outcomes for pancreatic cancer was made available thanks to a partnership between the University of Oxford, Oxford University Hospitals (OUH) NHS Foundation Trust and GenesisCare,
The cutting-edge radiotherapy machine is the only one of its kind in the UK, and with the support of the John Black Charitable Foundation, patients have started to have treatment on the ViewRay MRIdian machine.
Rob Stepney, who was diagnosed with prostate cancer in 2011, was one of the PACE-C clinical trial participants and was treated using the machine.

Chemotherapy
Making sure chemo is the right treatment, for the patient and for the NHS
Though chemotherapy, like radiotherapy, has been used for decades, the decision to use the treatment remains a balance between ensuring effectiveness and minimising side effects.
It’s also expensive. In 2016, chemotherapy cost NHS England £1.4 billion.
To help improve patient treatment experience, and reduce the financial burden for the NHS, researchers from the Health Economic Research Centre at Oxford investigated whether genetic testing could reduce adverse side effects and cut hospital costs.
Focusing on a particular chemotherapy drug type, fluoropyrimidines, the research team sought to find out whether taking a pre-emptive test could identify patients who are significantly more likely to experience adverse side effects during treatment.
‘Overall, this leads to substantial hospital cost savings per cancer patient treated with fluoropyrimidine-based chemotherapy’
If pre-emptive testing were applied before treatment started, and individuals at high risk of experiencing adverse side effects identified, the research team predicted an average hospital cost reduction of more than £20,000 per patient.
The impact chemotherapy has on the body
Although work is being done to minimise the adverse side effects of treatments like chemotherapy and radiotherapy, they can still have lasting effects on the body.
A study by Professor Nick Maynard of Oxford University Hospitals NHS Foundation Trust has assessed the changes in muscle-mass for patients with gastro-oesophageal cancer, to better understand the long-lasting effects of the therapies.
‘The discovery of the unexpected connection between DNA damage and food intake opens up opportunities to therapeutically interfere with this response, in order to improve the nutritional state of the many people undergoing cancer chemotherapy and children with Cockayne syndrome’
Researchers in the Patel group have also been investigating how chemotherapy impacts the body, shedding light on how DNA damage suppresses appetite.

Innovation
Innovation through collaboration
Technological advancements in the prevention, detection and treatment of cancer simply aren’t possible without the collaboration that takes place between universities, hospitals, clinical leaders and industry experts.
Such partnerships generate healthcare innovations, boost local economies and create jobs. Oxford’s Big Data Institute, for example, is home to the National Consortium of Medical Imaging (NCIMI).
A partnership between NHS trusts, companies, universities, charities and patient groups, the NCIMI aims to address unmet needs in cancer and other diseases by facilitating collaboration for clinical impact through artificial intelligence.
Industry partners involved in the consortium include Oxford spinouts Optellum and Perspectum.
‘At Oxford University, we are immensely proud of our spinouts and their pioneering innovations which have literally saved thousands of lives around the world’
Optellum, co-founded by Professor Sir Michael Brady, achieved a CE certification under the EU’s Medical Device Regulation for its Virtual Nodule Clinic in early 2022.
In October 2022, the Oxford-based company secured $14m in funding to advance their pioneering AI-powered lung cancer diagnosis technology.
This investment will allow the spinout to scale its UK and US base, operations and commercial launches, as well as expand its platform into personalised therapy decisions.
Previously, the company entered a strategic collaboration with the Lung Cancer Initiative at Johnson & Johnson, applying its AI-powered clinical decision support platform with the aim of increasing lung cancer survival rates.
Perspectum, fostered by Oxford’s culture of innovation and world-class medical teaching and research, developed the first mainstream applications of artificial intelligence using MRI to help treat metabolic disease.
Spinout successes
It’s not just in the sphere of medical imaging where technological innovations happen.
Singula Bio, co-founded by Professors Ahmed Ahmed, the late Enzo Cerundolo and Enda McVeigh, aims to become a world leader in therapies to use against difficult to treat diseases such as ovarian cancer. The biotechnology company will pioneer immunological, medical, surgical and computational technologies to generate therapies that eliminate cancer.
Technically a spinout of a spinout, immunotherapy company Immunocore raised $130m in Series B funding in 2020. Along with sister company Adaptimmune, Immunocore focuses on the development of immunotherapies that originated at the University.
These are concentrated on T cell receptor (TCR) therapies, which train T cells to differentiate between healthy and cancerous cells, enabling to target the cancerous cells more effectively.
Thanks to funding from the UKRI’s Impact Acceleration Account (IAA), Oxford spinout Alethiomics has also developed targeted and curative therapies for myeloproliferative neoplasms (MPNs) – a group of chronic blood cancers that begin with mutations that occur in cancer stem cells in the bone marrow.
Discover more spinout successes
Oxford Vacmedix
Oxford Vacmedix is a spinout of the University, founded by Professor Shisong Jiang from the Department of Oncology. The company is developing vaccines to treat cancer with the lead vaccine, OVM-200, in clinical trials.
OxSonics
Founded in 2013, OxSonics commercialises ground-breaking technological advances developed for more than 10 years at the University’s Biomedical Ultrasonics, Biotherapy and Biopharmaceutical Laboratory (BUBBL).
OXvax
OXvax Ltd. is a spinout company from the University of Oxford focused on the development of an advanced next generation dendritic cell vaccine platform for the treatment of solid tumour cancers.
Scenic Biotech
Spun out from the Netherlands Cancer Institute and Oxford University, Scenic Biotech focuses on identifying genetic modifiers for drug intervention, specialising in evolution inspired medicine for inherited rare diseases and cancer.
Vaccitech
A spinout company from the University of Oxford’s Jenner Institute, Vaccitech plc is a clinical T cell immunotherapy and vaccine company that develops products to treat and prevent infectious diseases, autoimmunity and cancer.
Xerion Healthcare
Following eight years of research, Xerion Healthcare was spun-out from the University in 2015. The company’s technology increases the ability of radiotherapy to kill cancer cells without harming healthy tissue.

Cancer vaccines and the impact of COVID-19
Building on the foundations of the COVID-19 vaccine
By using the technology behind the Oxford-AstraZeneca COVID-19 vaccine, Oxford researchers have designed a two-dose therapeutic vaccine to treat cancer.
The vaccine uses the same viral vector as the COVID jab, ChAdOx1. Unlike preventative vaccines for diseases like influenza, the cancer vaccine (VTP-600) is given to people who already have the disease.
‘This new vaccine platform has the potential to revolutionise cancer treatment’
The vaccine is designed to educate the immune system to identify highly-cancer specific surface molecules and attack cancer cells. It will be trialled in combination with standard checkpoint blockade immunotherapy and chemotherapy as part of the MAGE Cancer Vaccine (VTP-600) clinical trial.
The first patient in the trial, a patient with lung cancer, received their first dose of the cancer vaccine in January 2022.
The severity of COVID19 in cancer patients
Despite the Oxford-AstraZeneca jab providing potential treatment options for cancer, Oxford researchers found that cancer patients remain at higher risk of getting severe COVID-19 even after a third booster.
Led by Dr Lennard Lee, the UK Coronavirus Cancer Programme undertook a population-scale real-world evaluation of the third dose COVID-19 booster programme in over 360,000 UK patients with cancer.
The programme found that a recent cancer diagnosis, or having been treated with chemotherapy or radiotherapy in the previous 12 months, was associated with lower vaccine effectiveness.
‘We have undertaken the largest-real world health system evaluation of COVID-19 in cancer patients globally’
Prior to assessing the impact of the COVID-19 vaccine booster programme on patients with cancer, Dr Lennard Lee, with colleagues at the Universities of Birmingham and Southampton, and the UK Health Security Agency (UKHSA), looked at the effectiveness of the first two doses.
They found that, while the COVID-19 vaccination was effective in cancer patients, this waned more quickly in this group of individuals than in the general population. Looking at the differences between cancer types, they also found that effectiveness was lowest, and waned most quickly, in those who had the blood cancers lymphoma and leukaemia.
Researchers from the Molecular Haematology Unit at Oxford’s MRC-Weatherall Institute of Molecular Medicine (MRC-WIMM) also found that antibody responses to the first dose of the COVID-19 vaccine in patients with chronic myeloid blood cancers were not as strong as those in the general population.
Identifying cancer patients most at risk from COVID
As well as highlighting which cancer patients might receive reduced effectiveness from their COVID-19 vaccine, Oxford experts have also been identifying the types of cancer that present a higher risk to patients if they catch the virus itself.
Commissioned by England’s Chief Medical Officer Chris Whitty, a team of researchers led by Professor Julia Hippisley-Cox created the QCovid prediction tool, used by the NHS to assess patient vulnerability.
Based on the prediction tool, 1.7 million patients were added to the shielding list and 820,000 adults were prioritised for an earlier vaccination.
‘We have developed this new tool using the QResearch database, to help the NHS identify which patients are at highest risk of serious outcomes despite vaccination for targeted intervention.’
Having helped prioritise at-risk groups for initial vaccination doses, the research team were then able to use the QCovid tool to identify which vaccinated groups were more at risk of hospitalisation, or death, from COVID-19.
Impact of COVID on cancer detection and treatment
Also using data from QResearch and associated tools, Dr Defne Saatci has highlighted how COVID-19 had a detrimental effect on the early diagnosis, and subsequent treatment, of cancer in children and young adults.
The researchers found that children were more than twice as likely to be admitted to intensive care before their cancer was diagnosed, meaning treatment will have started at a later stage.
The work completed using such databases, in this instance concerning the impact of COVID-19 on cancer, shows how crucial it is for researchers to have access to, and an understanding of, public health data.

More from PULSE.